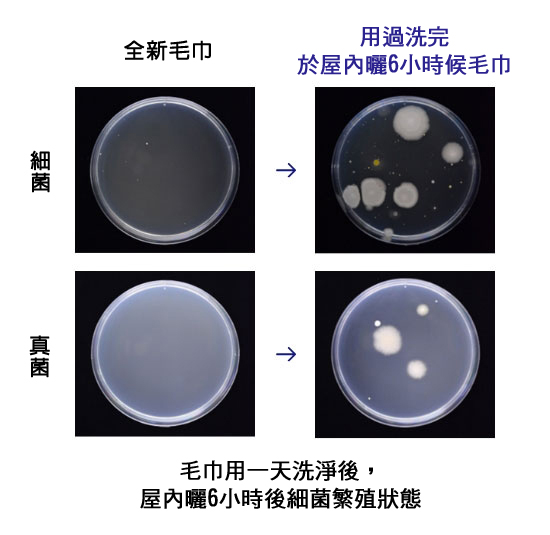

商品情報


添加玻尿酸.積雪草精華
柔潤呵護敏感肌
擔心毛巾摩擦過度
、洗完臉後常常有乾澀感…


肌膚容易敏感泛紅
擔心洗臉時又會過度刺激…

含玻尿酸、積雪草精華*
問題肌也安心
具保濕舒緩特性的玻尿酸.積雪草精華*
溫柔呵護敏感問題肌
*並非對肌膚有保濕效果
絲滑柔潤 溫和親膚

超柔細纖維,減輕摩擦
日本獨家開發含天然超柔細纖維,是一般毛巾絨1/20細緻,如絲綢般觸感,溫和親膚,減輕摩擦*,給您剛剛好的清潔。
*嬌聯研製
一般毛巾

充滿凹凸不平絨毛
絲花美顏洗臉巾

絲滑親膚的質感

本品化妝棉表層採用達到「生態紡織品標準100(OEKO-TEX)」中最嚴苛條件的「製品分類1(嬰幼兒製品)」纖維,是嬰兒肌膚也能用的高安全性產品。
蓬厚絲滑 柔潤 呵護敏感肌

蓬厚手感、大尺寸
可覆蓋全臉尺寸,怎麼用都方便
100%植物來由纖維,蓬厚不易破
在清潔使用後不過過度帶走肌膚水分
具絕佳吸水性
將水倒到托盤後放上洗臉巾,
幾乎所有水分都被吸收。
洗臉後只需輕柔按壓即可快速擦去水分

不會過度除去肌膚水分的特殊技術
嚴選精細材質及厚度, 使用後不過度帶走肌膚水分,
維持肌膚水潤感
毛巾容易成為細菌孳生的溫床
如果沒有定期更換、每次使用後立即清洗的話,
毛巾會成為細菌的溫床。
絲花洗臉巾為一次性洗臉巾,乾淨安心。
好抽不連張
簡約設計 居家好搭配


ティッシュのように、1枚ずつ取り出せるので便利!
白基調のシンプルパッケージデザインで
インテリアにもなじみます。
消費者使用評價
非常柔軟,摸起來很光滑舒服!


有保濕成分,使用起來有水潤感
感覺肌膚表面的水分很快被吸收,但肌膚內部的水分卻被牢牢鎖住了!


尺寸很大,面料厚實,非常好用
其他使用方法
沾水後不易破損,
乾溼兩用多用途

